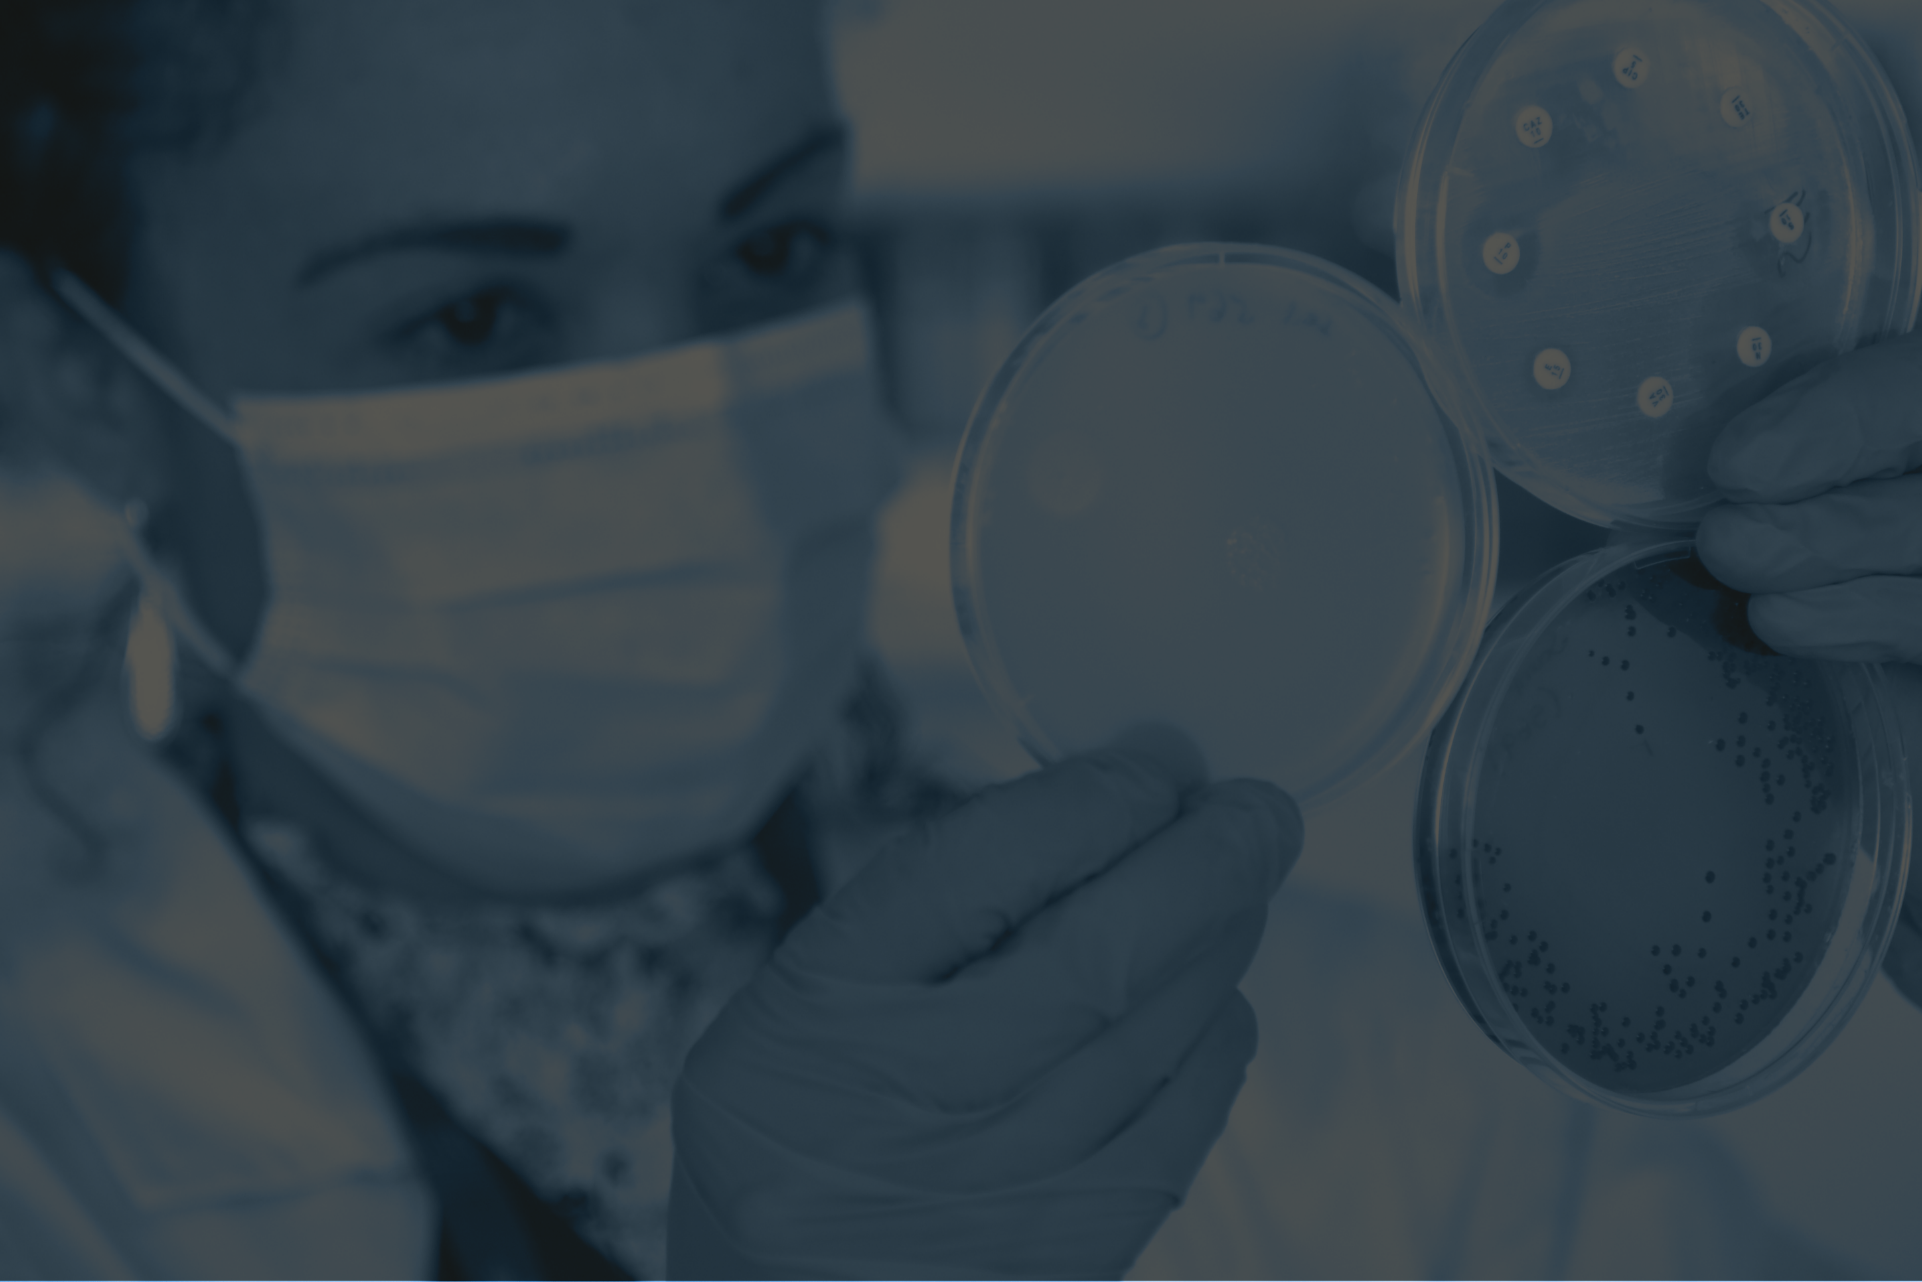
Laboratory

Diagnostics support outbreak detection, surveillance, treatment decisions, and targeted interventions. Strengthening these systems enables smarter, evidence-based disease management and improves livestock productivity.

This workshop brings together stakeholders from government, research, private sector, and development organizations to identify diagnostic gaps, share experiences, and develop practical solutions for strengthening livestock health systems in Kenya.
Key Objectives
- Identify and prioritize unmet diagnostic needs in ruminant livestock diseases
- Demonstrate how diagnostics support vaccination and treatment decisions
- Explore innovative diagnostic solutions and business models
- Develop a roadmap for integrating diagnostics into livestock health programs
Expected Outputs
- Consolidated workshop report with key findings and recommendations
- Prioritized list of diagnostic needs for livestock diseases
- Roadmap for improving diagnostic access and integration
- Stakeholder engagement and collaboration framework
- Policy and programmatic recommendations